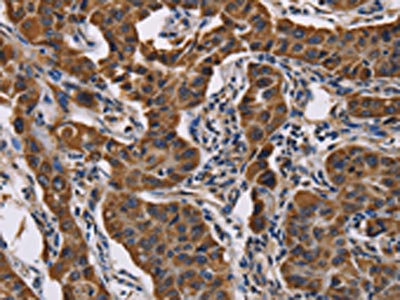

ADRBK2 Antibody
-
中文名稱(chēng):ADRBK2兔多克隆抗體
-
貨號(hào):CSB-PA913546
-
規(guī)格:¥1100
-
圖片:
-
The image on the left is immunohistochemistry of paraffin-embedded Human thyroid cancer tissue using CSB-PA913546(ADRBK2 Antibody) at dilution 1/50, on the right is treated with fusion protein. (Original magnification: ×200)
-
The image on the left is immunohistochemistry of paraffin-embedded Human lung cancer tissue using CSB-PA913546(ADRBK2 Antibody) at dilution 1/50, on the right is treated with fusion protein. (Original magnification: ×200)
-
-
其他:
產(chǎn)品詳情
-
Uniprot No.:
-
基因名:
-
別名:ADRBK2 antibody; Adrenergic; beta; receptor kinase 2 antibody; ARBK2_HUMAN antibody; BARK2 antibody; Beta adrenergic receptor kinase 2 antibody; Beta ARK 2 antibody; Beta-adrenergic receptor kinase 2 antibody; Beta-ARK-2 antibody; EC 2.7.11.15 antibody; G protein coupled receptor kinase 3 antibody; G-protein-coupled receptor kinase 3 antibody; GRK3 antibody
-
宿主:Rabbit
-
反應(yīng)種屬:Human,Mouse,Rat
-
免疫原:Fusion protein of Human ADRBK2
-
免疫原種屬:Homo sapiens (Human)
-
標(biāo)記方式:Non-conjugated
-
抗體亞型:IgG
-
純化方式:Antigen affinity purification
-
濃度:It differs from different batches. Please contact us to confirm it.
-
保存緩沖液:-20°C, pH7.4 PBS, 0.05% NaN3, 40% Glycerol
-
產(chǎn)品提供形式:Liquid
-
應(yīng)用范圍:ELISA,IHC
-
推薦稀釋比:
Application Recommended Dilution ELISA 1:1000-1:5000 IHC 1:50-1:200 -
Protocols:
-
儲(chǔ)存條件:Upon receipt, store at -20°C or -80°C. Avoid repeated freeze.
-
貨期:Basically, we can dispatch the products out in 1-3 working days after receiving your orders. Delivery time maybe differs from different purchasing way or location, please kindly consult your local distributors for specific delivery time.
-
用途:For Research Use Only. Not for use in diagnostic or therapeutic procedures.
相關(guān)產(chǎn)品
靶點(diǎn)詳情
-
功能:Specifically phosphorylates the agonist-occupied form of the beta-adrenergic and closely related receptors.
-
基因功能參考文獻(xiàn):
- Study found that GRK3 was significantly overexpressed in 162 pairs of colon cancer tissues than in the matched noncancerous mucosa. These data show that aberrant expression of GRK3 plays an important role in promoting colon cancer progression through enhanced proliferation and reduced apoptosis. PMID: 29445249
- hat expression of GRK3 was down-regulated in pancreatic ductal adenocarcinoma and was an independent prognostic factor PMID: 29254792
- GRK3 is a new critical activator of neuroendocrine phenotypes and mediator of CREB activation in promoting neuroendocrine differentiation of prostate cancer cells. PMID: 27191986
- effects of GRK3 modulation appear to be specific to chemokine-mediated migration behaviors without influencing tumor cell proliferation or survival PMID: 27049755
- data are consistent with the possibility that oncogenes can induce cellular stiffness via an HDAC6-induced reorganization of the vimentin intermediate filament network PMID: 24434559
- In oral squamous cell carcinomas, malignant cells and surrounding tissue overexpress the ADRBK2 gene. PMID: 21916780
- A reduced cortical concentration of GRK3 in schizophrenia (resembling that in aging) may result in altered G protein-dependent signaling, thus contributing to prefrontal deficits in schizophrenia. PMID: 21784156
- GRK3 is a negative regulator of cell growth whose expression is preferentially reduced in glioblastoma of the classical subtype as a consequence of activity in primary gliomagenic pathways. PMID: 22086906
- mRNA levels for GRK3 were inversely correlated with systolic and diastolic blood pressure (day, night and 24 h), which suggests a protective role for GRK3 in the regulation of human blood pressure PMID: 20216086
- we found no evidence of altered levels of acetylated histone H3 at the affected allele compared to the common allele PMID: 19766236
- dysregulation in GRK3 expression alters signaling desensitization, and thereby predisposes to the development of bipolar disorder PMID: 12808434
- the CRH-R1alpha carboxyl tail is important for regulation of receptor activity by G protein-coupled receptor kinase PMID: 15498832
- ATP stimulation leads to GRK3 phosphorylation of P2X(7) receptor. PMID: 15728711
- No support for a major role for GRK3 gene promoter variants in cocaine addiction. PMID: 17621168
- Dysregulation in GRK3 expression alters signaling desensitization and thereby predisposes to the development of bipolar disease. PMID: 18075471
- role for GRK3 in regulating CXCR4 attenuation and have provided a mechanistic link between the GRK3 pathway and the CXCR4-related WHIM(WT) disorder. PMID: 18274673
- The G-384A variant may alter binding of Sp1/Sp4 transcription factors resulting in an increase in gene transcription and an increase in vulnerability to bipolar disorder. PMID: 18359007
顯示更多
收起更多
-
蛋白家族:Protein kinase superfamily, AGC Ser/Thr protein kinase family, GPRK subfamily
-
數(shù)據(jù)庫(kù)鏈接:
Most popular with customers
-
-
YWHAB Recombinant Monoclonal Antibody
Applications: ELISA, WB, IHC, IF, FC
Species Reactivity: Human, Mouse, Rat
-
Phospho-YAP1 (S127) Recombinant Monoclonal Antibody
Applications: ELISA, WB, IHC
Species Reactivity: Human
-
-
-
-
-